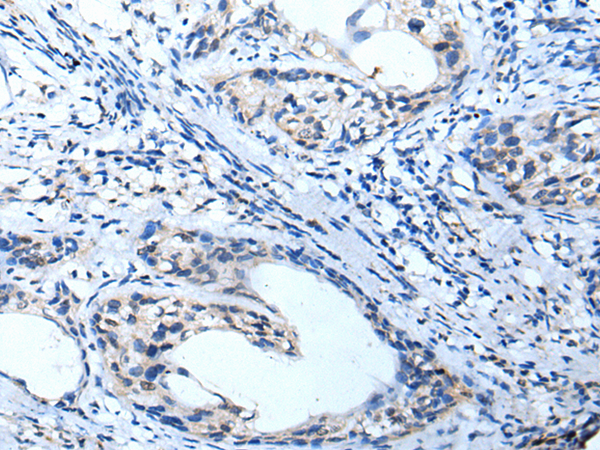

别名:MK3; HGK5; HLK3; PCN3; HPCN3; KV1.3; HUKIII应用:IHC
反应种属:Human, Mouse, Rat
规格:50μl/100μl
| Description |
|---|
| Potassium channels represent the most complex class of voltage-gated ion channels from both functional and structural standpoints. Their diverse functions include regulating neurotransmitter release, heart rate, insulin secretion, neuronal excitability, epithelial electrolyte transport, smooth muscle contraction, and cell volume. Four sequence-related potassium channel genes – shaker, shaw, shab, and shal – have been identified in Drosophila, and each has been shown to have human homolog(s). This gene encodes a member of the potassium channel, voltage-gated, shaker-related subfamily. This member contains six membrane-spanning domains with a shaker-type repeat in the fourth segment. It belongs to the delayed rectifier class, members of which allow nerve cells to efficiently repolarize following an action potential. It plays an essential role in T-cell proliferation and activation. This gene appears to be intronless and it is clustered together with KCNA2 and KCNA10 genes on chromosome 1. |
| Specification | |
|---|---|
| Aliases | MK3; HGK5; HLK3; PCN3; HPCN3; KV1.3; HUKIII |
| Swissprot | P22001 |
| Host/Isotype | Rabbit IgG |
| Storage | Store at 4°C short term. Aliquot and store at -20°C long term. Avoid freeze/thaw cycles. |
| Species Reactivity | Human, Mouse, Rat |
| Immunogen | Synthetic peptide of human KCNA3 |
| Formulation | pH7.4 PBS, 0.05% NaN3, 40% Glycerol |
| Application | |
|---|---|
| IHC | 1/20-1/100 |
| ELISA | 1/5000-1/10000 |
![]() |
The image is immunohistochemistry of paraffin-embedded Human tonsil tissue using P05897(KCNA3 Antibody) at dilution 1/35. (Original magnification: ×200) |
![]() |
The image is immunohistochemistry of paraffin-embedded Human cervical cancer tissue using P05897(KCNA3 Antibody) at dilution 1/35. (Original magnification: ×200) |
本公司的所有产品仅用于科学研究或者工业应用等非医疗目的,不可用于人类或动物的临床诊断或治疗,非药用,非食用。
暂无评论
本公司的所有产品仅用于科学研究或者工业应用等非医疗目的,不可用于人类或动物的临床诊断或治疗,非药用,非食用。
中文

发表回复